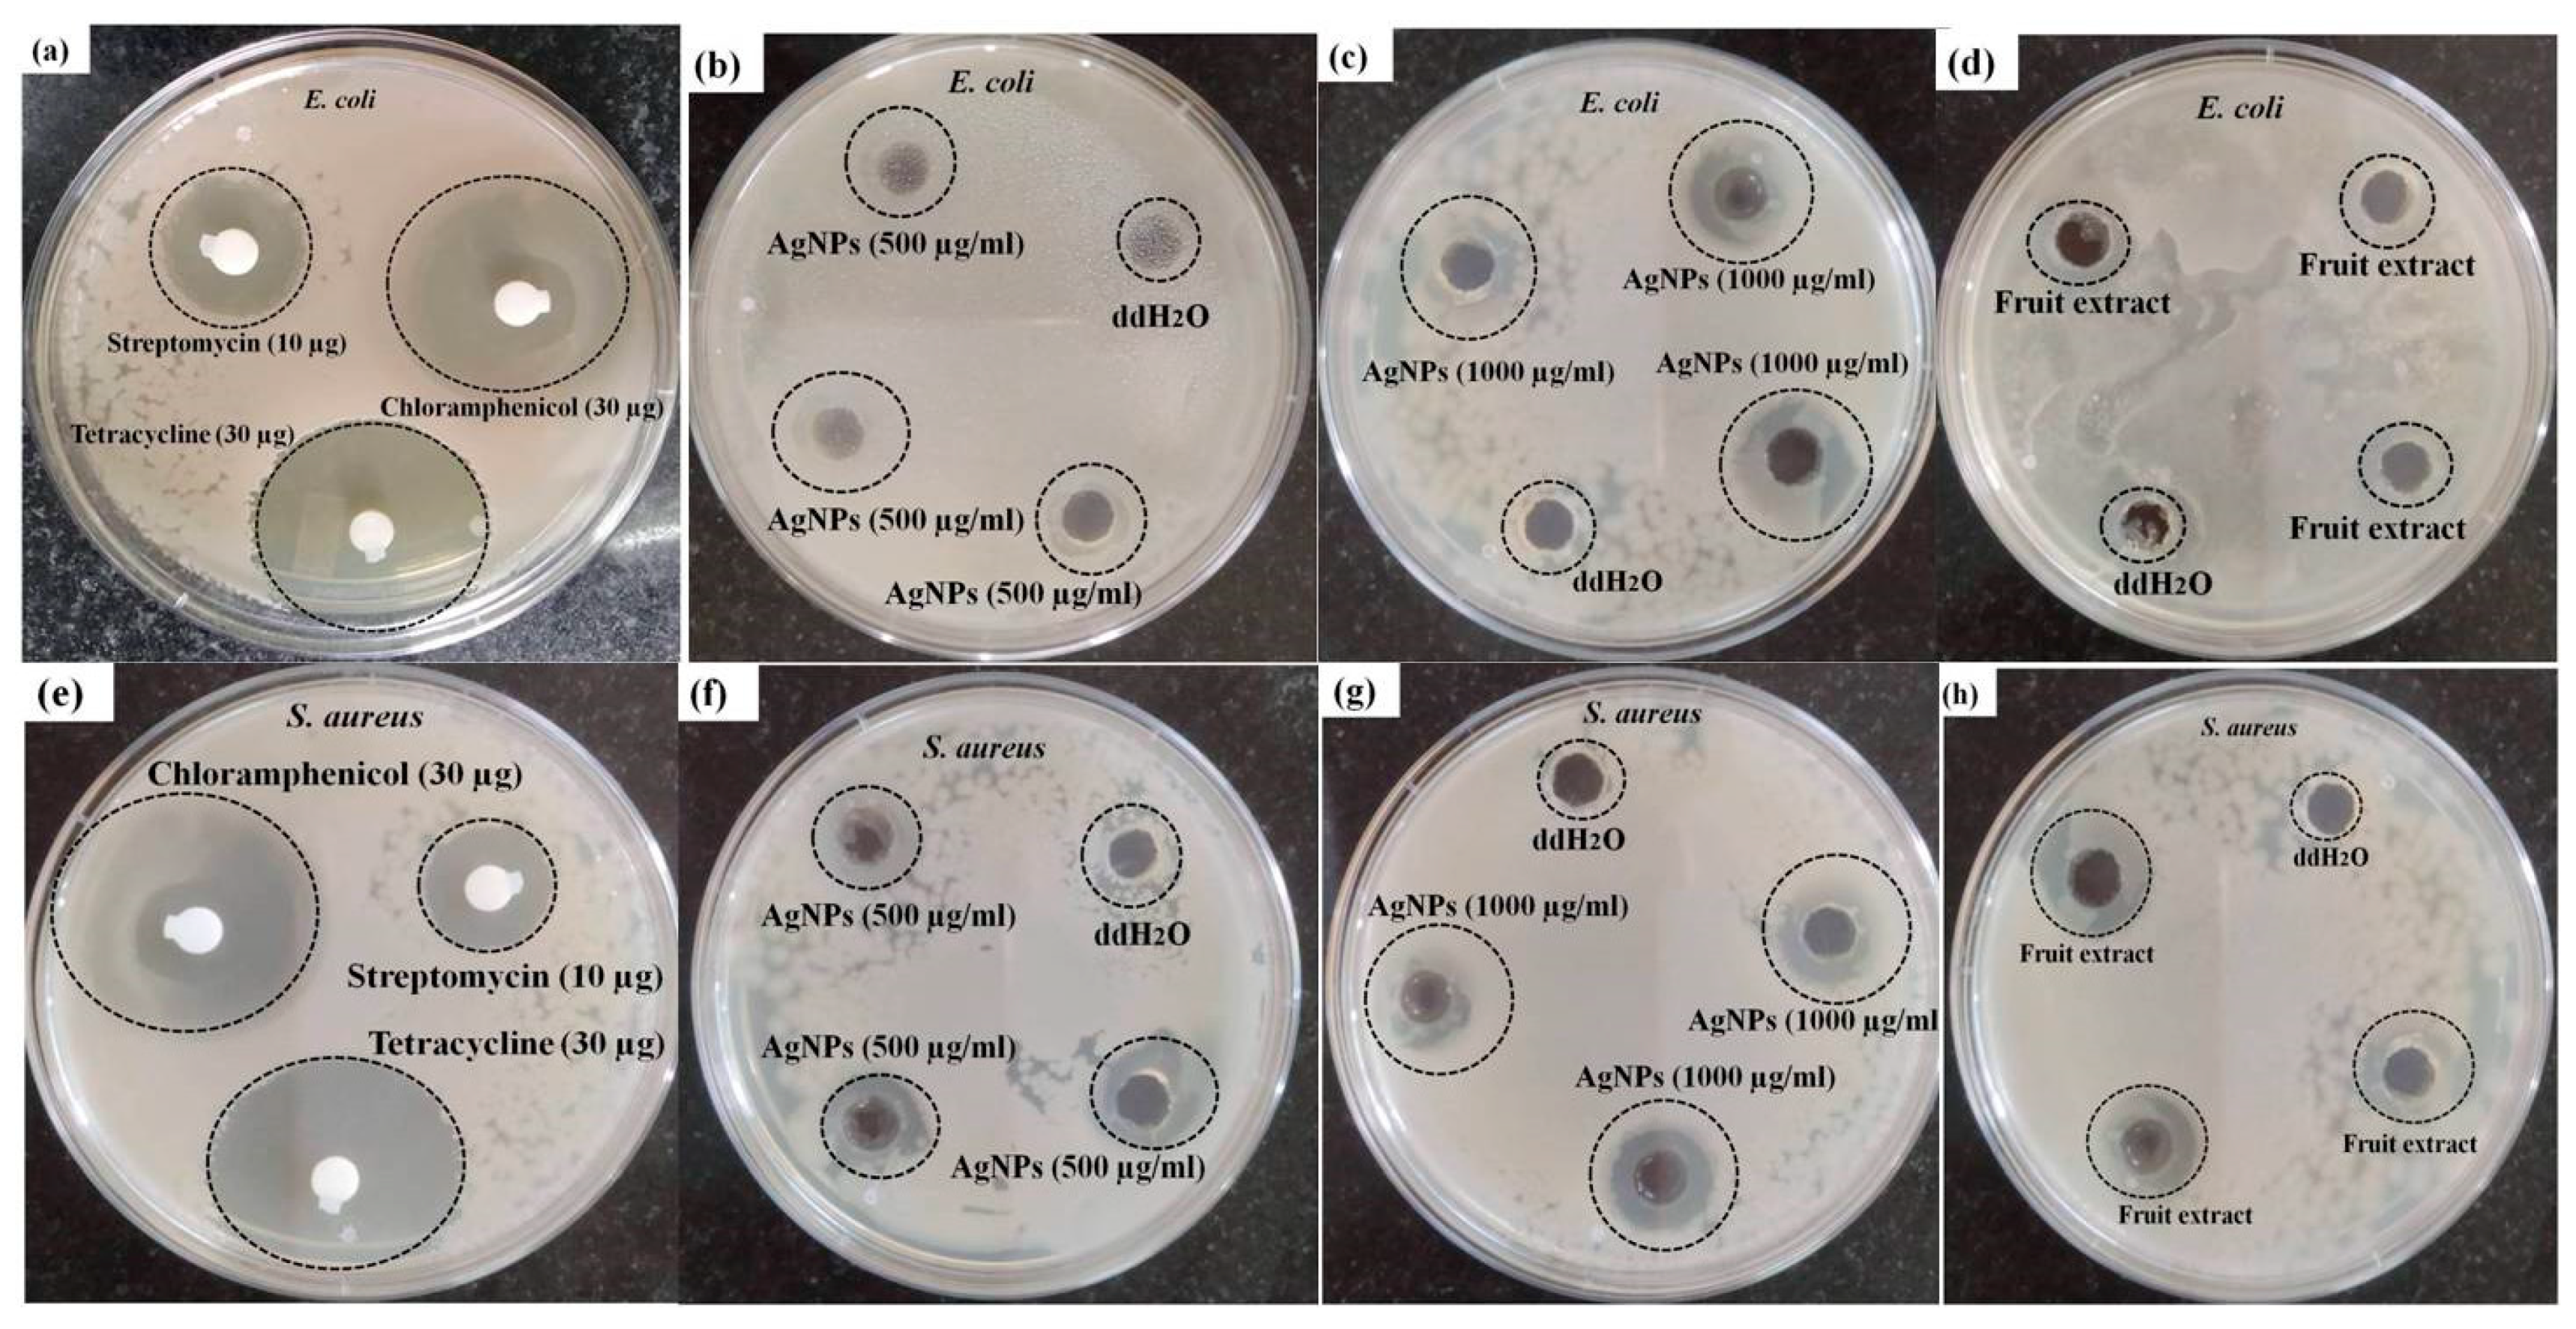
Nanomaterials 11 01999 g009

Green Synthesis of Silver Nanoparticles Using Diospyros malabarica Fruit Extract and Assessments of Their Antimicrobial, Anticancer and Catalytic Reduction of 4-Nitrophenol (4-NP)
Abstract
1. Introduction
2. Materials and Methods
2.1. Materials
2.2. Diospyros Malabarica (Aqueous) Fruit Extracts Preparation
2.3. Biosynthesis of AgNPs
2.4. Characterization of AgNPs
2.4.1. UV-Visible Spectroscopic Profile of Synthesized AgNPs
2.4.2. Stability of the Synthesized AgNPs
2.4.3. Transmission Electron Microscopy (TEM)
2.4.4. Field Emission Scanning Electron Microscope (FESEM) and Energy-Dispersive X-ray Spectroscopy (EDX)
2.4.5. PolydispersityIndex (PDI), Particle Size (DLS) and Zeta Potential (ζ)
2.4.6. X-ray Diffraction (XRD)
2.4.7. Fourier Transform Infrared (FTIR)
2.4.8. Photoluminescence (PL)
2.4.9. Antibacterial Activity of AgNPs
2.4.10. Assessment of Cytotoxicity in U87-MG Cells
Cell Morphology of AgNPs Treated U87-MG Cells
2.4.11. Live/Dead Assay
2.4.12. Catalytic Activity Test for Reduction of 4-Nitrophenol (4-NP)
3. Results and Discussion
3.1. Biosynthesis and Characterization of AgNPs
3.1.1. Color Change and UV-Visible Spectroscopic Profile of Synthesized AgNPs
3.1.2. TEM
3.1.3. FESEM and EDX Analysis
3.1.4. Particle Size and Zeta Potential (ζ) Analysis
3.1.5. XRD Analysis
3.1.6. FTIR Spectroscopy Analysis
3.1.7. Photoluminescence (PL) Studies
3.2. Antibacterial Activity of AgNPs
3.3. Cytotoxic Effect of AgNPs on U87-MG Cells
3.4. Live/Dead Assay Analysis
3.5. Catalytic Reduction of 4-Nitrophenol (4-NP)
4. Conclusions
Author Contributions
Funding
Institutional Review Board Statement
Data Availability Statement
Acknowledgments
Conflicts of Interest
References
- Mohanta, Y.K.; Nayak, D.; Biswas, K.; Singdevsachan, S.K.; Abd_Allah, E.F.; Hashem, A.; Alqarawi, A.A.; Yadav, D.; Mohanta, T.K. Silver nanoparticles synthesized using wild mushroom show potential antimicrobial activities against food borne pathogens. Molecules 2018, 23, 655. [Google Scholar] [CrossRef]
- Hamouda, R.A.; Hussein, M.H.; Abo-elmagd, R.A.; Bawazir, S.S. Synthesis and biological characterization of silver nanoparticles derived from the cyanobacterium Oscillatoria limnetica. Sci. Rep. 2019, 9, 13071. [Google Scholar] [CrossRef] [PubMed]
- Rabha, B.; Bharadwaj, K.K.; Baishya, D.; Sarkar, T.; Edinur, H.A.; Pati, S. Synthesis and characterization of diosgenin encapsulated poly-ε-caprolactone-pluronic nanoparticles and its effect on brain cancer cells. Polymers 2021, 13, 1322. [Google Scholar] [CrossRef]
- Govindarajan, M.; Rajeswary, M.; Veerakumar, K.; Muthukumaran, U.; Hoti, S.L.; Benelli, G. Green synthesis and characterization of silver nanoparticles fabricated using Anisomeles indica: Mosquitocidal potential against malaria, dengue and Japanese encephalitis vectors. Exp. Parasitol. 2016, 161, 40–47. [Google Scholar] [CrossRef]
- Saratale, R.G.; Benelli, G.; Kumar, G.; Kim, D.S.; Saratale, G.D. Bio-fabrication of silver nanoparticles using the leaf extract of an ancient herbal medicine, dandelion (Taraxacum officinale), evaluation of their antioxidant, anticancer potential, and antimicrobial activity against phytopathogens. Environ. Sci. Pollut. Res. 2018, 25, 10392–10406. [Google Scholar] [CrossRef] [PubMed]
- Schabes-Retchkiman, P.S.; Canizal, G.; Herrera-Becerra, R.; Zorrilla, C.; Liu, H.B.; Ascencio, J.A. Biosynthesis and characterization of Ti/Ni bimetallic nanoparticles. Opt. Mater. 2006, 29, 95–99. [Google Scholar] [CrossRef]
- Yokoyama, K.; Welchons, D.R. The conjugation of amyloid beta protein on the gold colloidal nanoparticles’ surfaces. Nanotechnology 2007, 18, 105101. [Google Scholar] [CrossRef]
- Mali, S.C.; Dhaka, A.; Githala, C.K.; Trivedi, R. Green synthesis of copper nanoparticles using Celastrus paniculatus Willd. leaf extract and their photocatalytic and antifungal properties. Biotechnol. Rep. 2020, 27, e00518. [Google Scholar] [CrossRef]
- Selim, Y.A.; Azb, M.A.; Ragab, I.; Abd El-Azim, M. Green synthesis of zinc oxide nanoparticles using aqueous extract of Deverra tortuosa and their cytotoxic activities. Sci. Rep. 2020, 10, 3445. [Google Scholar] [CrossRef]
- Huq, M.A. Green synthesis of silver nanoparticles using Pseudoduganella eburnea MAHUQ-39 and their antimicrobial mechanisms investigation against drug resistant human pathogens. Int. J. Mol. Sci. 2020, 21, 1510. [Google Scholar] [CrossRef]
- Kumar, B.; Smita, K.; Cumbal, L.; Debut, A. Green synthesis of silver nanoparticles using Andean blackberry fruit extract. Saudi J. Biol. Sci. 2017, 24, 45–50. [Google Scholar] [CrossRef]
- Lahiri, D.; Nag, M.; Sheikh, H.I.; Sarkar, T.; Edinur, H.; Siddhartha, P.; Ray, R. Microbiologically synthesized nanoparticles and their role in silencing the biofilm signaling cascade. Front. Microbiol. 2021. [CrossRef]
- Nag, M.; Lahiri, D.; Sarkar, T.; Ghosh, S.; Dey, A.; Edinur, H.A.; Pati, S.; Ray, R.R. Microbial fabrication of nanomaterial and its role in disintegration of exopolymeric matrices of biofilm. Front. Chem. 2021, 9, 690590. [Google Scholar] [CrossRef]
- Baharara, J.; Namvar, F.; Mousavi, M.; Ramezani, T.; Mohamad, R. Anti-angiogenesis effect of biogenic silver nanoparticles synthesized using Saliva officinalis on chick chorioalantoic membrane (CAM). Molecules 2014, 19, 13498–13508. [Google Scholar] [CrossRef] [PubMed]
- Ravichandran, V.; Vasanthi, S.; Shalini, S.; Shah, S.A.A.; Tripathy, M.; Paliwal, N. Green synthesis, characterization, antibacterial, antioxidant and photocatalytic activity of Parkia speciosa leaves extract mediated silver nanoparticles. Results Phys. 2019, 15, 102565. [Google Scholar] [CrossRef]
- Chinnasamy, G.; Chandrasekharan, S.; Koh, T.W.; Bhatnagar, S. Synthesis, characterization, antibacterial and wound healing efficacy of silver nanoparticles from Azadirachta indica. Front. Microbiol. 2021, 12, 611560. [Google Scholar] [CrossRef]
- Jain, N.; Jain, P.; Rajput, D.; Patil, U.K. Green synthesized plant-based silver nanoparticles: Therapeutic prospective for anticancer and antiviral activity. Micro Nano Syst. Lett. 2021, 9, 5. [Google Scholar] [CrossRef]
- Ghojavand, S.; Madani, M.; Karimi, J. Green synthesis, characterization and antifungal activity of silver nanoparticles using stems and flowers of felty germander. J. Inorg. Organomet. Polym. Mater. 2020, 30, 2987–2997. [Google Scholar] [CrossRef]
- El-Rafie, H.M.; Abdel-Aziz Hamed, M. Antioxidant and anti-inflammatory activities of silver nanoparticles biosynthesized from aqueous leaves extracts of four Terminalia species. Adv. Nat. Sci. Nanosci. Nanotechnol. 2014, 5, 035008. [Google Scholar] [CrossRef]
- Yuan, Y.-G.; Zhang, S.; Hwang, J.-Y.; Kong, I.-K. Silver nanoparticles potentiates cytotoxicity and apoptotic potential of camptothecin in human cervical cancer cells. Oxidative Med. Cell. Longev. 2018, 2018, 6121328. [Google Scholar] [CrossRef]
- Ishida, T. Anticancer activities of silver ions in cancer and tumor cells and DNA damages by Ag+-DNA base-pairs reactions. MOJ Tumor Res. 2017, 1, 8–16. [Google Scholar]
- David, L.; Moldovan, B.; Vulcu, A.; Olenic, L.; Perde-Schrepler, M.; Fischer-Fodor, E.; Florea, A.; Crisan, M.; Chiorean, I.; Clichici, S.; et al. Green synthesis, characterization and anti-inflammatory activity of silver nanoparticles using European black elderberry fruits extract. Colloids Surf. B. Biointerfaces 2014, 122, 767–777. [Google Scholar] [CrossRef]
- Shurpik, D.N.; Sevastyanov, D.A.; Zelenikhin, P.V.; Padnya, P.L.; Evtugyn, V.G.; Osin, Y.N.; Stoikov, I.I. Nanoparticles based on the zwitterionic pillar[5]arene and Ag(+): Synthesis, self-assembly and cytotoxicity in the human lung cancer cell line A549. Beilstein J. Nanotechnol. 2020, 11, 421–431. [Google Scholar] [CrossRef] [PubMed]
- Yudha, S.S.; Falahudin, A.; Wibowo, R.H.; Hendri, J.; Wicaksono, D.O. Reduction of 4-nitrophenol mediated by silver nanoparticles synthesized using aqueous leaf extract of Peronema canescens. Bull. Chem. React. Eng. Catal. 2021, 16. [Google Scholar] [CrossRef]
- Shimoga, G.; Palem, R.R.; Lee, S.-H.; Kim, S.-Y. Catalytic degradability of p-nitrophenol using ecofriendly silver nanoparticles. Metals 2020, 10, 1661. [Google Scholar] [CrossRef]
- Deka, P.; Deka, R.C.; Bharali, P. In situ generated copper nanoparticle catalyzed reduction of 4-nitrophenol. New J. Chem. 2014, 38, 1789–1793. [Google Scholar] [CrossRef]
- Khawas, P.; Dash, K.K.; Das, A.J.; Deka, S.C. Modeling and optimization of the process parameters in vacuum drying of culinary banana (Musa ABB) slices by application of artificial neural network and genetic algorithm. Dry. Technol. 2016, 34, 491–503. [Google Scholar] [CrossRef]
- Crisan, C.M.; Mocan, T.; Manolea, M.; Lasca, L.I.; Tăbăran, F.-A.; Mocan, L. Review on Silver nanoparticles as a novel class of antibacterial solutions. Appl. Sci. 2021, 11, 1120. [Google Scholar] [CrossRef]
- Padnya, P.; Gorbachuk, V.; Stoikov, I. The role of calix[n]arenes and pillar[n]arenes in the design of silver nanoparticles: Self-assembly and application. Int. J. Mol. Sci. 2020, 21, 1425. [Google Scholar] [CrossRef] [PubMed]
- Mehmood, A.; Murtaza, G.; Bhatti, T.M.; Raffi, M.; Kausar, R. Antibacterial efficacy of silver nanoparticles synthesized by a green method using bark extract of Melia azedarach L. J. Pharm. Innov. 2014, 9, 238–245. [Google Scholar] [CrossRef]
- Teimuri-mofrad, R.; Hadi, R.; Tahmasebi, B.; Farhoudian, S.; Mehravar, M.; Nasiri, R. Green synthesis of gold nanoparticles using plant extract: Mini-review. Nanochem. Res. 2017, 2, 8–19. [Google Scholar] [CrossRef]
- Johnson, P.; Krishnan, V.; Loganathan, C.; Govindhan, K.; Raji, V.; Sakayanathan, P.; Vijayan, S.; Sathishkumar, P.; Palvannan, T. Rapid biosynthesis of Bauhinia variegata flower extract-mediated silver nanoparticles: An effective antioxidant scavenger and α-amylase inhibitor. Artif. Cells Nanomed. Biotechnol. 2018, 46, 1488–1494. [Google Scholar] [CrossRef]
- Kumar, B.; Smita, K.; Cumbal, L.; Angulo, Y. Fabrication of silver nanoplates using Nephelium lappaceum (Rambutan) peel: A sustainable approach. J. Mol. Liq. 2015, 211, 476–480. [Google Scholar] [CrossRef]
- Chand, K.; Cao, D.; Eldin Fouad, D.; Hussain Shah, A.; Qadeer Dayo, A.; Zhu, K.; Nazim Lakhan, M.; Mehdi, G.; Dong, S. Green synthesis, characterization and photocatalytic application of silver nanoparticles synthesized by various plant extracts. Arab. J. Chem. 2020, 13, 8248–8261. [Google Scholar] [CrossRef]
- Shaik, M.R.; Khan, M.; Kuniyil, M.; Al-Warthan, A.; Alkhathlan, H.Z.; Siddiqui, M.R.H.; Shaik, J.P.; Ahamed, A.; Mahmood, A.; Khan, M.; et al. Plant-extract-assisted green synthesis of silver nanoparticles using Origanum vulgare L. extract and their microbicidal activities. Sustainability 2018, 10, 913. [Google Scholar] [CrossRef]
- Swilam, N.; Nematallah, K.A. Polyphenols profile of pomegranate leaves and their role in green synthesis of silver nanoparticles. Sci. Rep. 2020, 10, 14851. [Google Scholar] [CrossRef]
- Behravan, M.; Hossein Panahi, A.; Naghizadeh, A.; Ziaee, M.; Mahdavi, R.; Mirzapour, A. Facile green synthesis of silver nanoparticles using Berberis vulgaris leaf and root aqueous extract and its antibacterial activity. Int. J. Biol. Macromol. 2019, 124, 148–154. [Google Scholar] [CrossRef] [PubMed]
- Elemike, E.E.; Onwudiwe, D.C.; Nundkumar, N.; Singh, M.; Iyekowa, O. Green synthesis of Ag, Au and Ag-Au bimetallic nanoparticles using Stigmaphyllon ovatum leaf extract and their in vitro anticancer potential. Mater. Lett. 2019, 243, 148–152. [Google Scholar] [CrossRef]
- Soliman, W.E.; Khan, S.; Rizvi, S.M.; Moin, A.; Elsewedy, H.S.; Abulila, A.S.; Shehata, T.M. Therapeutic applications of biostable silver nanoparticles synthesized using peel extract of Benincasa hispida: Antibacterial and anticancer activities. Nanomaterials 2020, 10, 1954. [Google Scholar] [CrossRef]
- Tyavambiza, C.; Elbagory, A.M.; Madiehe, A.M.; Meyer, M.; Meyer, S. The antimicrobial and anti-inflammatory effects of silver nanoparticles synthesised from Cotyledon orbiculata aqueous extract. Nanomaterials 2021, 11, 1343. [Google Scholar] [CrossRef] [PubMed]
- Yasmin, S.; Nouren, S.; Bhatti, H.N.; Iqbal, D.N.; Iftikhar, S.; Majeed, J.; Mustafa, R.; Nisar, N.; Nisar, J.; Nazir, A.; et al. Green synthesis, characterization and photocatalytic applications of silver nanoparticles using Diospyros lotus. Green Process. Synth. 2020, 9, 87–96. [Google Scholar] [CrossRef]
- Mukunthan, K.S.; Elumalai, E.K.; Patel, T.N.; Murty, V.R. Catharanthus roseus: A natural source for the synthesis of silver nanoparticles. Asian Pac. J. Trop. Biomed. 2011, 1, 270–274. [Google Scholar] [CrossRef]
- Sathishkumar, P.; Preethi, J.; Vijayan, R.; Mohd Yusoff, A.R.; Ameen, F.; Suresh, S.; Balagurunathan, R.; Palvannan, T. Anti-acne, anti-dandruff and anti-breast cancer efficacy of green synthesised silver nanoparticles using Coriandrum sativum leaf extract. J. Photochem. Photobiol. B 2016, 163, 69–76. [Google Scholar] [CrossRef] [PubMed]
- Moteriya, P.; Chanda, S. Synthesis and characterization of silver nanoparticles using Caesalpinia pulcherrima flower extract and assessment of their in vitro antimicrobial, antioxidant, cytotoxic, and genotoxic activities. Artif. Cells Nanomed. Biotechnol. 2017, 45, 1556–1567. [Google Scholar] [CrossRef]
- Anandalakshmi, K.; Venugobal, J.; Ramasamy, V. Characterization of silver nanoparticles by green synthesis method using Pedalium murex leaf extract and their antibacterial activity. Appl. Nanosci. 2016, 6, 399–408. [Google Scholar] [CrossRef]
- de Jesús Ruíz-Baltazar, Á.; Reyes-López, S.Y.; Larrañaga, D.; Estévez, M.; Pérez, R. Green synthesis of silver nanoparticles using a Melissa officinalis leaf extract with antibacterial properties. Results Phys. 2017, 7, 2639–2643. [Google Scholar] [CrossRef]
- Arya, G.; Kumari, R.M.; Gupta, N.; Kumar, A.; Chandra, R.; Nimesh, S. Green synthesis of silver nanoparticles using Prosopis juliflora bark extract: Reaction optimization, antimicrobial and catalytic activities. Artif. Cells Nanomed. Biotechnol. 2018, 46, 985–993. [Google Scholar] [CrossRef]
- Dehghanizade, S.; Arasteh, J.; Mirzaie, A. Green synthesis of silver nanoparticles using Anthemis atropatana extract: Characterization and in vitro biological activities. Artif. Cells Nanomed. Biotechnol. 2018, 46, 160–168. [Google Scholar] [CrossRef] [PubMed]
- Sinha, B.N.; Bansal, S. A review of phytochemical and biological studies of Diospyros species used in folklore medicine of Jharkhand. J. Nat. Remed. 2008, 8, 11–17. [Google Scholar]
- Shubhra, R.D.; Polash, S.A.; Saha, T.; Hasan, A.; Hossain, S.; Islam, Z.; Sarker, S.R. Investigation of the phytoconstituents and antioxidant activity of Diospyros malabarica fruit extracts. Adv. Biosci. Biotechnol. 2019, 10, 431–454. [Google Scholar] [CrossRef][Green Version]
- Saeb, A.T.M.; Alshammari, A.S.; Al-Brahim, H.; Al-Rubeaan, K.A. Production of silver nanoparticles with strong and stable antimicrobial activity against highly pathogenic and multidrug resistant bacteria. Sci. World J. 2014, 2014, 704708. [Google Scholar] [CrossRef] [PubMed]
- Osibe, D.A.; Chiejina, N.V.; Ogawa, K.; Aoyagi, H. Stable antibacterial silver nanoparticles produced with seed-derived callus extract of Catharanthus roseus. Artif. Cells Nanomed. Biotechnol. 2018, 46, 1266–1273. [Google Scholar] [CrossRef]
- Pati, S.; Chatterji, A.; Dash, B.P.; Nelson, B.R.; Sarkar, T.; Shahimi, S.; Edinur, H.A.; Abd Manan, T.S.B.; Jena, P.; Mohanta, Y.K.; et al. Structural characterization and antioxidant potential of chitosan by γ-irradiation from the carapace of horseshoe crab. Polymers 2020, 2361. [Google Scholar] [CrossRef]
- Pati, S.; Sarkar, T.; Sheikh, H.I.; Bharadwaj, K.K.; Mohapatra, P.K.; Chatterji, A.; Dash, B.P.; Edinur, H.A.; Nelson, B.R. γ-irradiated chitosan from Carcinoscorpius rotundicauda (Latreille, 1802) improves the shelf life of refrigerated aquatic products. Front. Mar. Sci. 2021, 8, 498. [Google Scholar] [CrossRef]
- Balouiri, M.; Sadiki, M.; Ibnsouda, S.K. Methods for in vitro evaluating antimicrobial activity: A review. J. Pharm. Anal. 2016, 6, 71–79. [Google Scholar] [CrossRef]
- Bethu, M.S.; Netala, V.R.; Domdi, L.; Tartte, V.; Janapala, V.R. Potential anticancer activity of biogenic silver nanoparticles using leaf extract of Rhynchosia suaveolens: An insight into the mechanism. Artif. Cells Nanomed. Biotechnol. 2018, 46, 104–114. [Google Scholar] [CrossRef] [PubMed]
- Jini, D.; Sharmila, S. Green synthesis of silver nanoparticles from Allium cepa and its in vitro antidiabetic activity. Mater. Today Proc. 2020, 22, 432–438. [Google Scholar] [CrossRef]
- Hernández-Morales, L.; Espinoza-Gómez, H.; Flores-López, L.Z.; Sotelo-Barrera, E.L.; Núñez-Rivera, A.; Cadena-Nava, R.D.; Alonso-Núñez, G.; Espinoza, K.A. Study of the green synthesis of silver nanoparticles using a natural extract of dark or white Salvia hispanica L. seeds and their antibacterial application. Appl. Surf. Sci. 2019, 489, 952–961. [Google Scholar] [CrossRef]
- Arya, G.; Kumari, R.M.; Sharma, N.; Gupta, N.; Kumar, A.; Chatterjee, S.; Nimesh, S. Catalytic, antibacterial and antibiofilm efficacy of biosynthesised silver nanoparticles using Prosopis juliflora leaf extract along with their wound healing potential. J. Photochem. Photobiol. B. 2019, 190, 50–58. [Google Scholar] [CrossRef] [PubMed]
- Sangaonkar, G.M.; Pawar, K.D. Garcinia indica mediated biogenic synthesis of silver nanoparticles with antibacterial and antioxidant activities. Colloids Surf. B Biointerfaces 2018, 164, 210–217. [Google Scholar] [CrossRef]
- Garibo, D.; Borbón-Nuñez, H.A.; de León, J.N.D.; García Mendoza, E.; Estrada, I.; Toledano-Magaña, Y.; Tiznado, H.; Ovalle-Marroquin, M.; Soto-Ramos, A.G.; Blanco, A.; et al. Green synthesis of silver nanoparticles using Lysiloma acapulcensis exhibit high-antimicrobial activity. Sci. Rep. 2020, 10, 12805. [Google Scholar] [CrossRef] [PubMed]
- Salari, S.; Esmaeilzadeh Bahabadi, S.; Samzadeh-Kermani, A.; Yosefzaei, F. In-vitro evaluation of antioxidant and antibacterial potential of greensynthesized silver nanoparticles using Prosopis farcta fruit extract. Iran. J. Pharm. Res. IJPR 2019, 18, 430–455. [Google Scholar]
- Jahan, I.; Erci, F.; Isildak, I. Microwave-assisted green synthesis of non-cytotoxic silver nanoparticles using the aqueous extract of Rosa santana (rose) petals and their antimicrobial activity. Anal. Lett. 2019, 52, 1860–1873. [Google Scholar] [CrossRef]
- Karwa, A.; Gaikwad, S.; Rai, M.K. Mycosynthesis of silver nanoparticles using Lingzhi or Reishi medicinal mushroom, Ganoderma lucidum (W. Curt.:Fr.) P. Karst. and their role as antimicrobials and antibiotic activity enhancers. Int. J. Med. Mushrooms 2011, 13, 483–491. [Google Scholar] [CrossRef] [PubMed]
- Ashokkumar, S.; Ravi, S.; Kathiravan, V.; Velmurugan, S. Synthesis, characterization and catalytic activity of silver nanoparticles using Tribulus terrestris leaf extract. Spectrochim. Acta Part A Mol. Biomol. Spectrosc. 2014, 121, 88–93. [Google Scholar] [CrossRef]
- Venugobal, J.; Anandalakshmi, K. Green synthesis of silver nanoparticles using Commiphora caudata leaves extract and the study of bactericidal efficiency. J. Clust. Sci. 2016, 27, 1683–1699. [Google Scholar] [CrossRef]
- Vinay, S.P.; Udayabhanu; Nagarju, G.; Chandrappa, C.P.; Chandrasekhar, N. Enhanced photocatalysis, photoluminescence, and anti-bacterial activities of nanosize Ag: Green synthesized via Rauvolfia tetraphylla (devil pepper). SN Appl. Sci. 2019, 1, 477. [Google Scholar] [CrossRef]
- Ajitha, B.; Ashok Kumar Reddy, Y.; Sreedhara Reddy, P. Green synthesis and characterization of silver nanoparticles using Lantana camara leaf extract. Mater. Sci. Eng. C 2015, 49, 373–381. [Google Scholar] [CrossRef] [PubMed]
- Gomathi, A.C.; Xavier Rajarathinam, S.R.; Mohammed Sadiq, A.; Rajeshkumar, S. Anticancer activity of silver nanoparticles synthesized using aqueous fruit shell extract of Tamarindus indica on MCF-7 human breast cancer cell line. J. Drug Deliv. Sci. Technol. 2020, 55, 101376. [Google Scholar] [CrossRef]
- Govindan, L.; Anbazhagan, S.; Altemimi, A.B.; Lakshminarayanan, K.; Kuppan, S.; Pratap-Singh, A.; Kandasamy, M. Efficacy of antimicrobial and larvicidal activities of green synthesized silver nanoparticles using leaf extract of Plumbago auriculata Lam. Plants 2020, 9, 577. [Google Scholar] [CrossRef]
- Hemlata; Meena, P.R.; Singh, A.P.; Tejavath, K.K. Biosynthesis of silver nanoparticles using Cucumis prophetarum aqueous leaf extract and their antibacterial and antiproliferative activity against cancer cell lines. ACS Omega 2020, 5, 5520–5528. [Google Scholar] [CrossRef]
- Venkatadri, B.; Shanparvish, E.; Rameshkumar, M.R.; Arasu, M.V.; Al-Dhabi, N.A.; Ponnusamy, V.K.; Agastian, P. Green synthesis of silver nanoparticles using aqueous rhizome extract of Zingiber officinale and Curcuma longa: In-vitro anti-cancer potential on human colon carcinoma HT-29 cells. Saudi J. Biol. Sci. 2020, 27, 2980–2986. [Google Scholar] [CrossRef]
- Zhang, X.-F.; Park, J.-H.; Choi, Y.-J.; Kang, M.-H.; Gurunathan, S.; Kim, J.-H. Silver nanoparticles cause complications in pregnant mice. Int. J. Nanomed. 2015, 10, 7057–7071. [Google Scholar] [CrossRef]
- Awwad, A.M.; Salem, N.M.; Abdeen, A.O. Green synthesis of silver nanoparticles using carob leaf extract and its antibacterial activity. Int. J. Ind. Chem. 2013, 4, 29. [Google Scholar] [CrossRef]
- Shanmuganathan, R.; MubarakAli, D.; Prabakar, D.; Muthukumar, H.; Thajuddin, N.; Kumar, S.S.; Pugazhendhi, A. An enhancement of antimicrobial efficacy of biogenic and ceftriaxone-conjugated silver nanoparticles: Green approach. Environ. Sci. Pollut. Res. Int. 2018, 25, 10362–10370. [Google Scholar] [CrossRef] [PubMed]
- Pirtarighat, S.; Ghannadnia, M.; Baghshahi, S. Green synthesis of silver nanoparticles using the plant extract of Salvia spinosa grown in vitro and their antibacterial activity assessment. J. Nanostruct. Chem. 2019, 9, 1–9. [Google Scholar] [CrossRef]
- Cheng, K.; Hung, Y.; Chen, C.; Liu, C.; Young, J. Green synthesis of chondroitin sulfate-capped silver nanoparticles: Characterization and surface modification. Carbohydr. Polym. 2014, 110, 195–202. [Google Scholar] [CrossRef]
- Verma, A.; Mehata, M.S. Controllable synthesis of silver nanoparticles using Neem leaves and their antimicrobial activity. J. Radiat. Res. Appl. Sci. 2016, 9, 109–115. [Google Scholar] [CrossRef]
- Bhati, A.; Anand, S.R.; Saini, D.; Khare, P.; Dubey, P.; Sonkar, S.K. Self-doped nontoxic red-emitting Mg–N-embedded carbon dots for imaging, Cu(ii) sensing and fluorescent ink. New J. Chem. 2018, 42, 19548–19556. [Google Scholar] [CrossRef]
- Gao, Z.; Hao, Y.; Zheng, M.; Chen, Y. A fluorescent dye with large Stokes shift and high stability: Synthesis and application to live cell imaging. RSC Adv. 2017, 7, 7604–7609. [Google Scholar] [CrossRef]
- Patir, K.; Gogoi, S.K. Facile synthesis of photoluminescent graphitic carbon nitride quantum dots for Hg2+ detection and room temperature phosphorescence. ACS Sustain. Chem. Eng. 2018, 6, 1732–1743. [Google Scholar] [CrossRef]
- Hasabeldaim, E.H. CIE chromaticity diagram 1931 2021.
- Francis, S.; Joseph, S.; Koshy, E.P.; Mathew, B. Microwave assisted green synthesis of silver nanoparticles using leaf extract of Elephantopus scaber and its environmental and biological applications. Artif. Cells Nanomed. Biotechnol. 2018, 46, 795–804. [Google Scholar] [CrossRef]
- Taranath, T.; Hedaginal, B.; Rajani, P.; Sindhu, M. Phytosynthesis of silver nanoparticles using the leaf extract of Diospyros malabarica (desr.) Kostel and its antibacterial activity against human pathogenic gram negative Escherichia coli and Pseudomonas aeruginosa. Int. J. Pharm. Sci. Rev. Res. 2015, 30, 109–114. [Google Scholar]
- Mohamed, D.S.; Abd El-Baky, R.M.; Sandle, T.; Mandour, S.A.; Ahmed, E.F. Antimicrobial activity of silver-treated bacteria against other multi-drug resistant pathogens in their environment. Antibiotics 2020, 9, 181. [Google Scholar] [CrossRef]
- Javan bakht Dalir, S.; Djahaniani, H.; Nabati, F.; Hekmati, M. Characterization and the evaluation of antimicrobial activities of silver nanoparticles biosynthesized from Carya illinoinensis leaf extract. Heliyon 2020, 6, e03624. [Google Scholar] [CrossRef]
- Loo, Y.Y.; Rukayadi, Y.; Nor-Khaizura, M.-A.-R.; Kuan, C.H.; Chieng, B.W.; Nishibuchi, M.; Radu, S. In vitro antimicrobial activity of green synthesized silver nanoparticles against selected gram-negative foodborne pathogens. Front. Microbiol. 2018, 9, 1555. [Google Scholar] [CrossRef]
- Satpathy, S.; Patra, A.; Ahirwar, B.; Delwar Hussain, M. Antioxidant and anticancer activities of green synthesized silver nanoparticles using aqueous extract of tubers of Pueraria tuberosa. Artif. Cells Nanomed. Biotechnol. 2018, 46, S71–S85. [Google Scholar] [CrossRef] [PubMed]
- Mousavi, B.; Tafvizi, F.; Zaker Bostanabad, S. Green synthesis of silver nanoparticles using Artemisia turcomanica leaf extract and the study of anti-cancer effect and apoptosis induction on gastric cancer cell line (AGS). Artif. Cells Nanomed. Biotechnol. 2018, 46, 499–510. [Google Scholar] [CrossRef]
- Liu, X.; Shan, K.; Shao, X.; Shi, X.; He, Y.; Liu, Z.; Jacob, J.A.; Deng, L. Nanotoxic effects of silver nanoparticles on normal HEK-293 cells in comparison to cancerous HeLa cell line. Int. J. Nanomed. 2021, 16, 753–761. [Google Scholar] [CrossRef] [PubMed]
- Kong, Y.; Paray, B.A.; Al-Sadoon, M.K.; Fahad Albeshr, M. Novel green synthesis, chemical characterization, toxicity, colorectal carcinoma, antioxidant, anti-diabetic, and anticholinergic properties of silver nanoparticles: A chemopharmacological study. Arab. J. Chem. 2021, 14, 103193. [Google Scholar] [CrossRef]
- Sarkar, S.; Kotteeswaran, V. Green synthesis of silver nanoparticles from aqueous leaf extract of Pomegranate (Punica granatum) and their anticancer activity on human cervical cancer cells. Adv. Nat. Sci. Nanosci. Nanotechnol. 2018, 9, 025014. [Google Scholar] [CrossRef]
- Prasannaraj, G.; Venkatachalam, P. Green engineering of biomolecule-coated metallic silver nanoparticles and their potential cytotoxic activity against cancer cell lines. Adv. Nat. Sci. Nanosci. Nanotechnol. 2017, 8, 025001. [Google Scholar] [CrossRef]
- Hajrezaie, M.; Paydar, M.; Looi, C.Y.; Moghadamtousi, S.Z.; Hassandarvish, P.; Salga, M.S.; Karimian, H.; Shams, K.; Zahedifard, M.; Majid, N.A.; et al. Apoptotic effect of novel Schiff based CdCl₂ (C₁₄H₂₁N₃O₂) complex is mediated via activation of the mitochondrial pathway in colon cancer cells. Sci. Rep. 2015, 5, 9097. [Google Scholar] [CrossRef] [PubMed]
- Rahbar Saadat, Y.; Saeidi, N.; Zununi Vahed, S.; Barzegari, A.; Barar, J. An update to DNA ladder assay for apoptosis detection. Bioimpacts 2015, 5, 25–28. [Google Scholar] [CrossRef]

Publisher’s Note: MDPI stays neutral with regard to jurisdictional claims in published maps and institutional affiliations. |
© 2021 by the authors. Licensee MDPI, Basel, Switzerland. This article is an open access article distributed under the terms and conditions of the Creative Commons Attribution (CC BY) license (https://creativecommons.org/licenses/by/4.0/).
Share and Cite
Bharadwaj, K.K.; Rabha, B.; Pati, S.; Choudhury, B.K.; Sarkar, T.; Gogoi, S.K.; Kakati, N.; Baishya, D.; Kari, Z.A.; Edinur, H.A. Green Synthesis of Silver Nanoparticles Using Diospyros malabarica Fruit Extract and Assessments of Their Antimicrobial, Anticancer and Catalytic Reduction of 4-Nitrophenol (4-NP). Nanomaterials 2021, 11, 1999. https://doi.org/10.3390/nano11081999
Bharadwaj KK, Rabha B, Pati S, Choudhury BK, Sarkar T, Gogoi SK, Kakati N, Baishya D, Kari ZA, Edinur HA. Green Synthesis of Silver Nanoparticles Using Diospyros malabarica Fruit Extract and Assessments of Their Antimicrobial, Anticancer and Catalytic Reduction of 4-Nitrophenol (4-NP). Nanomaterials. 2021; 11(8):1999. https://doi.org/10.3390/nano11081999
Chicago/Turabian StyleBharadwaj, Kaushik Kumar, Bijuli Rabha, Siddhartha Pati, Bhabesh Kumar Choudhury, Tanmay Sarkar, Sonit Kumar Gogoi, Nayanjyoti Kakati, Debabrat Baishya, Zulhisyam Abdul Kari, and Hisham Atan Edinur. 2021. "Green Synthesis of Silver Nanoparticles Using Diospyros malabarica Fruit Extract and Assessments of Their Antimicrobial, Anticancer and Catalytic Reduction of 4-Nitrophenol (4-NP)" Nanomaterials 11, no. 8: 1999. https://doi.org/10.3390/nano11081999
APA StyleBharadwaj, K. K., Rabha, B., Pati, S., Choudhury, B. K., Sarkar, T., Gogoi, S. K., Kakati, N., Baishya, D., Kari, Z. A., & Edinur, H. A. (2021). Green Synthesis of Silver Nanoparticles Using Diospyros malabarica Fruit Extract and Assessments of Their Antimicrobial, Anticancer and Catalytic Reduction of 4-Nitrophenol (4-NP). Nanomaterials, 11(8), 1999. https://doi.org/10.3390/nano11081999

